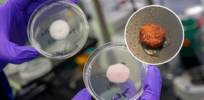
‘Mold burgers’: The source of your favorite sandwich might be a bit unconventional in the future

Talker News
‘Mold burgers’: The source of your favorite sandwich might be a bit unconventional in the future
Genetically altered mold could be the future of food, providing tasty, healthy and environmentally friendly snacks. New research suggests that ...


